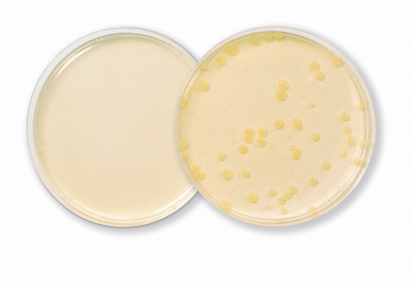

MXV medium
Bacterial spot is an important bacterial disease of peppers.Two different bacteria, Xanthomonas campestris pv. vesicatoria (Xcv) and Xanthomonas vesicatoria (Xv) can incite this seed borne disease. MXV medium is a semi-selective medium for detection of Xcv and Xv on seeds of pepper and tomato. The colonies of Xcv on MXV plates utilize Tween 80 and are yellow and mucoid. Contaminated seed lots can be detected by dilution plating of the bacterial extract on mTMB, CKTM or mKM. Suspected isolates are then transferred to YDC. Finally, the identity of the suspected isolates can be deter-mined by a pathogenicity test or PCR. For detailed information about Duchefa’s Phytopathological media have a look at our specialized brochure about this topic. Brochure can be found at the “Brochure section” at the home page of this website.